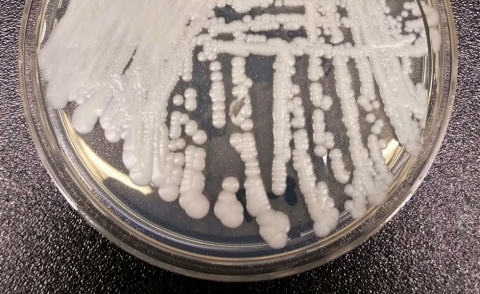

Del Viernes, 30 de Enero de 2026 al Sábado, 31 de Enero de 2026
ACTUALIDAD
Jóvenes españoles navegan entre la presión y la motivación en septiembre
Casi la mitad de los encuestados entre 20 y 34 años se siente atrapado en un ciclo de expectativas y autoexigencia, según un estudio de bienestar mental.
La vuelta a la rutina tras el verano genera una montaña rusa emocional especialmente intensa entre los jóvenes españoles. Un estudio realizado esta semana por Unobravo, en colaboración con la empresa de análisis Dynata, revela que los españoles de 20 a 24 años son el grupo con sensaciones más contradictorias: un 49% sufre estrés y un 47% asegura sentir motivación al mismo tiempo.
El informe destaca que un 48% de los jóvenes de hasta 34 años se siente frecuentemente atrapado en un ciclo de presión, una cifra que contrasta con el 31% registrado en el grupo de 45 a 55 años. Esta brecha generacional apunta a que los más jóvenes afrontan la reincorporación laboral y académica con una mayor carga mental y autoexigencia.
Expertos consultados atribuyen este fenómeno a varios factores concurrentes. La cultura del éxito inmediato, la incertidumbre sobre el futuro profesional y la presión ejercida por las redes sociales crean un cóctel que intensifica la sensación de agobio. La exposición constante a vidas aparentemente perfectas en Internet incrementa la ansiedad y el sentimiento de no estar a la altura de las expectativas.
A nivel general, las emociones negativas dominan el espectro sentimental en septiembre. El estrés (35,4%) es la más común, seguida de la ansiedad (28%), la tristeza (23%) y la nostalgia (21,5%). Solo una cuarta parte de la población (25%) experimenta motivación.
Francisco Rivera, Manager Clínico de Unobravo en España, señaló que “volver a la rutina tras el verano es un reto psicológico para la mayoría” y que estas emociones “son reacciones normales a un cambio abrupto”. El especialista recomendó “promover la corresponsabilidad para aliviar las cargas” y planificar una vuelta gradual a las obligaciones para ganar sensación de control.
El estudio también identifica las principales preocupaciones: la incertidumbre financiera (34%) y la sobrecarga mental (32%) se sitúan a la cabeza, seguidas de las expectativas laborales (28,8%) y la gestión de las rutinas familiares (26,3%).

La vuelta a la rutina tras el verano genera una montaña rusa emocional especialmente intensa entre los jóvenes españoles. Un estudio realizado esta semana por Unobravo, en colaboración con la empresa de análisis Dynata, revela que los españoles de 20 a 24 años son el grupo con sensaciones más contradictorias: un 49% sufre estrés y un 47% asegura sentir motivación al mismo tiempo.
El informe destaca que un 48% de los jóvenes de hasta 34 años se siente frecuentemente atrapado en un ciclo de presión, una cifra que contrasta con el 31% registrado en el grupo de 45 a 55 años. Esta brecha generacional apunta a que los más jóvenes afrontan la reincorporación laboral y académica con una mayor carga mental y autoexigencia.
Expertos consultados atribuyen este fenómeno a varios factores concurrentes. La cultura del éxito inmediato, la incertidumbre sobre el futuro profesional y la presión ejercida por las redes sociales crean un cóctel que intensifica la sensación de agobio. La exposición constante a vidas aparentemente perfectas en Internet incrementa la ansiedad y el sentimiento de no estar a la altura de las expectativas.
A nivel general, las emociones negativas dominan el espectro sentimental en septiembre. El estrés (35,4%) es la más común, seguida de la ansiedad (28%), la tristeza (23%) y la nostalgia (21,5%). Solo una cuarta parte de la población (25%) experimenta motivación.
Francisco Rivera, Manager Clínico de Unobravo en España, señaló que “volver a la rutina tras el verano es un reto psicológico para la mayoría” y que estas emociones “son reacciones normales a un cambio abrupto”. El especialista recomendó “promover la corresponsabilidad para aliviar las cargas” y planificar una vuelta gradual a las obligaciones para ganar sensación de control.
El estudio también identifica las principales preocupaciones: la incertidumbre financiera (34%) y la sobrecarga mental (32%) se sitúan a la cabeza, seguidas de las expectativas laborales (28,8%) y la gestión de las rutinas familiares (26,3%).

Normas de participación
Esta es la opinión de los lectores, no la de este medio.
Nos reservamos el derecho a eliminar los comentarios inapropiados.
La participación implica que ha leído y acepta las Normas de Participación y Política de Privacidad
Normas de Participación
Política de privacidad
Por seguridad guardamos tu IP
216.73.216.168